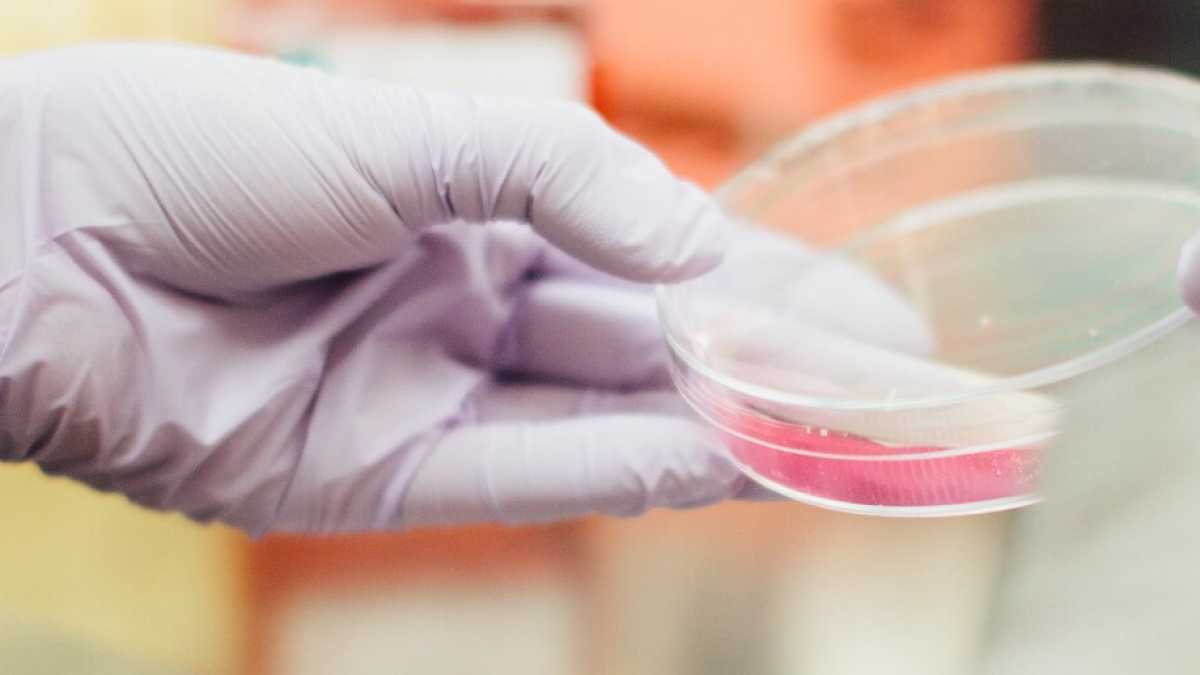
Immagine di Per il vaccino anti-Covid gli animalisti preferiscono le cavie umane

Per il vaccino anti-Covid gli animalisti preferiscono le cavie umane
"I ricercatori di tutto il mondo lavorano ogni giorno anche a metodi alternativi, ma finché non ce ne sono la scelta sarà tra sperimentare sull'uomo o sugli animali", dice il direttore di Research4Life Giuliano Grignaschi
Foto di Drew Hays via Unsplash
L'emergenza coronavirus ha metto il silenziatore a molte castronerie no vax. Sono in tanti adesso, ad attendere (e il prima possibile) una soluzione farmacologica al nuovo patogeno che da due mesi ci tiene chiusi in casa e che ha già provocato, stando alle cifre ufficiali, più di 25 mila morti. Ormai è chiaro ad altrettanti cittadini italiani che, per avere un soluzione valida, servono anche i test sugli animali: una procedura importante nella ricerca e nella verifica della sicurezza dei nuovi prodotti. Come scrivevamo sul Foglio parlando della ricerca al vaccino anti-Covid, infatti, una volta che si è identificato un potenziale vaccino, si passa alla cosiddetta "sperimentazione preclinica": si tratta di studi in laboratorio "che utilizzano colture di cellule (in vitro) e modelli animali (in vivo) per valutare la risposta immunitaria, l’efficacia protettiva del vaccino da sviluppare e il suo profilo di sicurezza". Conclusa quella fase, e se i dati ottenuti in laboratorio indicano che il vaccino è abbastanza sicuro ed efficace, si passa alla sperimentazione nell’uomo (detta "clinica"), suddivisa in quattro fasi: le prime tre prima di mettere in commercio il vaccino, l'ultima è rappresentata dagli studi svolti in seguito.
Per garantire la validità e soprattutto la sicurezza di questi farmaci, al momento non ci sono alternative efficaci. Eppure c'è ancora chi contesta la sperimentazione animale. "Chi lo fa sostiene – di fatto – l’idea di fare test anche molto preliminari (e quindi pericolosi) direttamente sull’uomo", dice Research4Life (R4L), la piattaforma che riunisce moltissimi autorevoli ricercatori italiani. Giuliano Grignaschi, direttore di R4L e socio fondatore del Patto traversale per la scienza, spiega che sostenere, come fa la Lega anti-vivisezione (Lav) in un comunicato, che è necessaria una ricerca "human- based" - sviluppata per l'uomo e sull'uomo - significa proporre di sperimentare direttamente sull'uomo, quindi senza aver testato prima i parametri di efficacia, sicurezza e tossicità come oggi solo la sperimentazione animale consente. "Una retorica vuota - dice Grignaschi - che rischia di causare altre morti, un cumulo di frasi anche offensive per chi sta lavorando per contribuire a liberare il mondo da Covid-19".
È importante sottolineare che questa sciagurata strategia non solo esporrebbe i primi volontari a rischi inaccettabili (chi farebbe il volontario?) ma rallenterebbe anche moltissimo le tempistiche e nel frattempo la pandemia continuerebbe ad uccidere migliaia di esseri umani.
Secondo il think tank di ricercatori, parlare di test fallimentari sugli animali per Covid-19 è da irresponsabili, perché in tutto il mondo la sperimentazione è la base e il presupposto della ricerca biomedica. È proprio attraverso tentativi, errori, fallimenti e successi che si consolidano cure, si scoprono medicine e vaccini. Proprio come è stato nel caso del vaccino contro Ebola che - contrariamente a quanto afferma Lav - ha dimostrato eccome la sua straordinaria efficacia, fermando quella che in questo caso potremmo davvero definire una "strage silenziosa", perché colpiva le popolazioni più povere e remote dell'Africa.
"Da ultimo mi preme sottolineare - continua Grignaschi - che la scienza è altamente democratica e chi dice di disporre di nuovi metodi deve solo dimostrare che funzionano: con i fatti però, non con le chiacchiere. I ricercatori di tutto il mondo si impegnano e lavorano ogni giorno anche per trovare metodi alternativi, ma fino a quando non ci riusciremo la scelta sarà tra sperimentare su cavie umane o animali".
